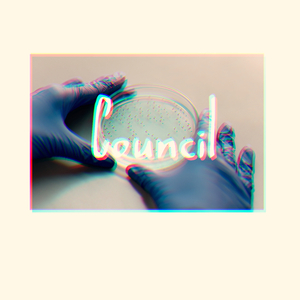
Logging

Logging (Original Mix)
Citlali Rojas

Logging (Original Mix)
Citlali Rojas

Longing
X JAPAN

Longing
Yansen Alvor

longing
reverie.

Longing
Domizia Drake

Logging
Last Horse Standing
Logging
Gregory Harrison

Longing
Joakim Karud

Longing
Matteo Myderwyk

Logging (Original Mix)
Citlali Rojas

Longing
Red Cedar

longing
神田沙也加

Longing
Jacoo

偷个闲
十八logging

登录
马思唯

Log
Mrs. GREEN APPLE, サカグチアミ

长安乱
十八logging, 翊歌Yier, 竹卿坊

坐忘道
十八logging

Login
しるこ, PIKASONIC

华夏
十八logging

听说我喜欢你
十八logging, 蒛蒛

欲买桂花同载酒
十八logging

腾龙,梦开始的地方
LONG

赛跑开点
LOG

LOG 1
LOG

LOG 7
LOG

LOG 2
LOG

LOG 3
LOG

LOG 9
LOG